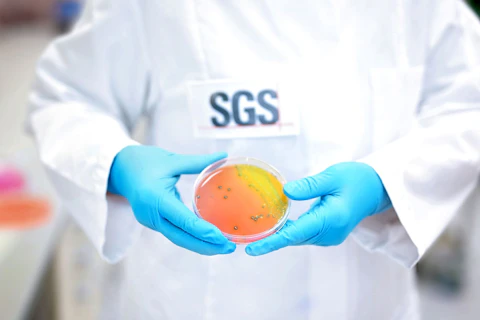
SGS Microbiology Services Lab Hamburg, Germany

Webinar Type
Webinar Topic
Date
58 results found

Avoid FDA/FTC Compliance Pitfalls: Labeling Strategies for Dietary Supplements
Join us for a complimentary webinar focusing on compliance strategies for ensuring FDA/FTC regulatory approval for dietary supplements labeling.
Watch on-demand
Driving Sustainable Food Service: The PLEDGE on Food Waste Certification with SGS
Join this webinar to discover how hospitality and food service businesses can effectively reduce food waste, boost sustainability, and enhance their reputation through The PLEDGE on Food Waste.
Watch on-demand
Natural Products Amidst the GLP-1 Craze: Research, Regulation and Reach
Join our experts to discover how to design clinical trials for natural health products and dietary supplements that mimic, complement, or address GLP-1 effects. Learn what regulatory pathways are available to help maximize success.
Watch on-demand
FSMA 204 Food Traceability Solutions Launch – Audits, Training and TRAKKEY Software
Join our webinar to explore our full service portfolio for FSMA 204 compliance.
Watch on-demand
The GLP-1 Craze Decoded: Current Research and Regulatory Insights for the Nutra Industry
Explore the latest trends, regulations and market research in a complimentary webinar covering the exciting field of hormone-based health solutions.
Watch on-demand
Dietary Supplements under US FDA: Ensuring Label and Claim Compliance
Join our expert-led webinar to gain valuable insights into US FDA dietary supplement labeling regulations, ensuring compliance, claim accuracy and consumer safety while navigating common pitfalls and evolving industry standards.
Watch on-demand
Explore EU plans to ban BPA and bisphenols in food contact products
Join our live webinar to gain insight into the EU’s plan to ban BPA and bisphenols in food contact products.
Watch on-demand
Microbiota Matters: Optimize Your Clinical Trial Design for Quality Results
Join our live webinar to gain insight into how to optimize clinical trials for quality results, the benefits of the S.T.O.R.M.S checklist and much more.
Watch on-demand
Unlocking the Secrets of Food Safety: A Deep Dive into Microbiological Challenge Testing
Join our live webinar to gain insight into microbiological challenge testing, significant details regarding the tests, case studies and much more.
Watch on-demand
Unlocking the Power of Digital PCR for Food Safety and Authenticity
Join our live webinar to gain insight into SGS’s portfolio of digital PCR methods to address food safety and authenticity issues in key areas and much more.
Watch on-demand